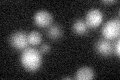
YMR025W

View description
Subunit of the Cop9 signalosome, which is required for deneddylation, or removal of the ubiquitin-like protein Rub1p from Cdc53p (cullin); involved in adaptation to pheromone signaling
Localization:
Intensity:
Fold change:
Significance:
-
C’ GFP library in SD

below threshold17.55 -
N' NOP1pr-GFP in SD

cytosol32.0546 -
N' TEF2pr-mCherry in SD

cytosol10.342 -
N' NATIVEpr-GFP in SD

below threshold25.4752 -
N' TEF2pr-VC and Cyto-VN in SD

#N/A0 -
C’ GFP library in SD+DTT
cytosol17.50.99No -
C’ GFP library in SD+H2O2

cytosol15.840.9No -
C’ GFP library in Starvation Media

cytosol21.881.24No -
C’ GFP library on the background of Pup2-DaMP

below threshold -
C’ GFP library on the background of CCT mutant

below threshold16.7770.955478No
